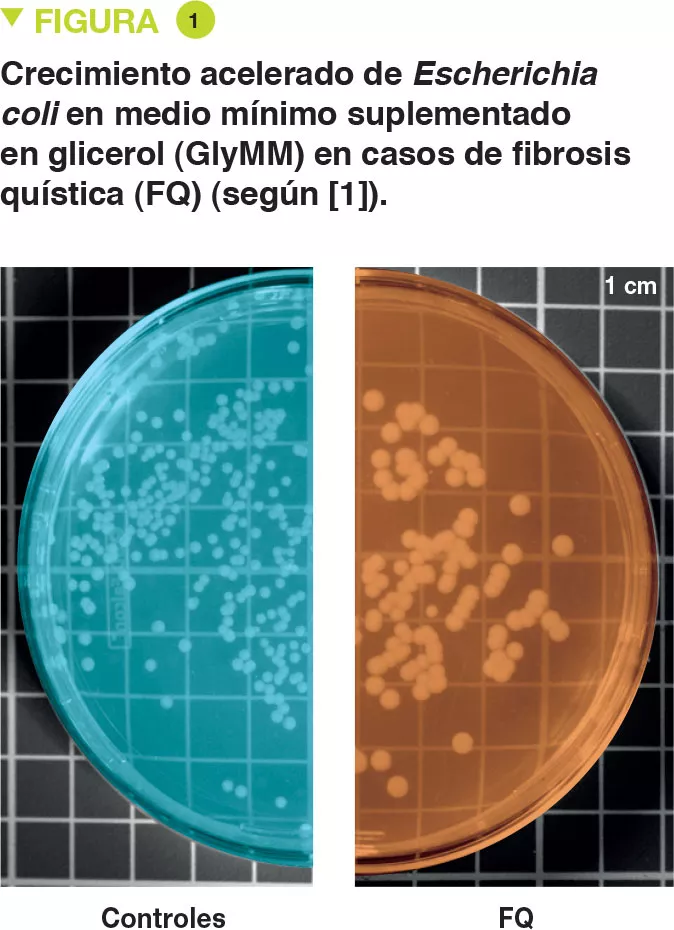

Adaptación de Escherichia coli comensales en el tracto intestinal de los niños de corta edad con mucoviscidosis
Artículo comentado - niño
By Pr. Emmanuel Mas
Gastroenterology and Nutrition Department, Children’s Hospital, Toulouse, France
Espacio para el público general
Encuentra aquí tu espacio dedicadoen_sources_title
en_sources_text_start en_sources_text_end
Capítulos

Acerca de este artículo
Comentario del artículo original de Matamouros et al. (PNAS 2018)
La microbiota del intestino humano maduro se establece durante los primeros años de vida, y la presencia de alteraciones en los microbiomas intestinales se ha asociado con diversos trastornos de salud. Habitualmente, Escherichia coli representa menos de un 1 % del microbioma intestinal humano. Sin embargo, en los casos de fibrosis quística (FQ) es habitual encontrar abundancias relativas superiores al 50 %, que van asociadas a la inflamación intestinal y la malabsorción de grasa fecal. A pesar de la proliferación de E. coli y de otras proteobacterias en condiciones ligadas a la inflamación crónica del tracto gastrointestinal, se sabe muy poco sobre la adaptación de las características específicas asociadas a la expansión clonal de la microbiota.
Este estudio ha demostrado que E. coli aisladas de muestras fecales procedentes de niños de corta edad con FQ se han adaptado a crecer en presencia de glicerol, un componente importante de la grasa fecal. Las cepas de E. coli aisladas de diferentes pacientes con FQ muestran una mayor tasa de crecimiento en presencia de glicerol que las E. coli procedentes de controles sanos, y cepas de E. coli de grupos con FQ no relacionadas han adquirido este rasgo de crecimiento de forma independiente. Además, las cepas de E. coli aisladas de los grupos con FQ y control presentan una expresión genética diferencial cuando se cultivan en medios mínimos, con glicerol como única fuente de carbono. Las cepas aisladas de los grupos con FQ muestran un perfil transcripcional que favorece el crecimiento, mientras que las cepas aisladas de los grupos control presentan estrés y programas de fase estacionaria, lo que se traducirá probablemente en una menor tasa de crecimiento. Estos resultados indican que hay una selección de características únicas en el microbioma de los individuos con FQ, lo cual podría contribuir al desarrollo individual de la enfermedad. [1]
¿Qué ya se sabe de este tema?
La principal alteración digestiva que provoca la mucoviscidosis es la insuficiencia pancreática exocrina, que está presente en un 85 % de los casos y requiere de la administración de suplementos de extractos pancreáticos. A pesar de esta suplementación, la malabsorción de grasas puede persistir. En general, el porcentaje de Escherichia coli en el microbioma intestinal humano es inferior al 1 %, pero su presencia puede llegar al 70-80 % en los casos de mucoviscidosis. Aunque hay una expansión clonal intrapaciente, las cepas son distintas entre individuos, lo que sugiere la existencia de una adaptación de E. coli a su entorno. Algunas cepas de E. coli están implicadas en la inflamación intestinal y el cáncer colorrectal. La mucoviscidosis va acompañada de inflamación digestiva, disbiosis y, en ocasiones, aumento del riesgo de cáncer colorrectal según los datos más recientes.
Los autores han propuesto la hipótesis de que en la mucoviscidosis se produce una selección de cepas de E. coli capaces de sobrevivir en medios intestinales con un elevado contenido en grasas y una mucosa anormal.
¿Cuáles son los principales resultados brindados por este estudio?
Se aisló E. coli procedente de heces de 6 niños de corta edad que padecían mucoviscidosis y de 2 controles. Los autores evaluaron el crecimiento de estas bacterias en un medio mínimo cuya única fuente de carbono eran los suplementos de glucosa (GluMM) o glicerol (GlyMM). En las placas con GlyMM, el crecimiento de E. coli es más rápido en el caso de las cepas aisladas de niños con mucoviscidosis que en el de aquellas aisladas de los controles (Figura 1). Estas diferencias no se observaron en condiciones anaerobias. Dado que el medio intestinal es básicamente anaerobio, es posible que el oxígeno desempeñe un papel importante. Cerca del epitelio existe un gradiente mínimo de oxígeno.
El análisis genético demostró que las cepas de E. coli eran distintas. Por otra parte, las 8 cepas aisladas presentaban más de 11 000 SNP (single nucleotide polymorphisms, polimorfismos de un solo nucleótido) que aparecieron en uno o varios niños afectados por mucoviscidosis, pero que estaban ausentes en los controles. Se llevó a cabo el análisis transcriptómico (RNA-seq) en medio GluMM o GlyMM de cepas aisladas de 2 niños con mucoviscidosis y 2 controles, siendo seleccionadas estas cepas por su crecimiento en medio GlyMM y su posición en el árbol filogenético. Entre los genes con expresión diferencial, 213 presentaron sobreexpresión (absorción y metabolismo del glicerol) y 6 subexpresión (transporte celular de la glucosa) en medio GlyMM, tanto en niños con mucoviscidosis como en los controles. En medio GluMM hubo una expresión diferencial de solamente 20 genes entre los niños con mucoviscidosis y los controles, frente a los 405 genes en medio GlyMM (377 genes no inducidos en la mucoviscidosis) (Figura 2). Estos genes con subexpresión en casos de mucoviscidosis en medio GlyMM codificaban para proteínas implicadas en el estrés, la resistencia a los ácidos y la formación de biofilm. Los genes con sobreexpresión en los casos de mucoviscidosis o con subexpresión en los controles codificaban para proteínas implicadas en los mecanismos de crecimiento. En los casos de mucoviscidosis, el incremento del crecimiento en medio GlyMM no estaría relacionado con una reprogramación metabólica, sino con la pérdida de la inhibición del crecimiento y de la respuesta al estrés.

Puntos clave
-
La mucoviscidosis va asociada a una disbiosis a nivel intestinal. Destaca sobre todo el incremento en la proporción de E. coli.
-
Debido a la malabsorción de grasas, se produce un aumento de glicerol a nivel intestinal. Estas cepas de E. coli seleccionadas en la mucoviscidosis se han adaptado a estas condiciones gracias a una expresión diferencial de algunos genes y una pérdida de la inhibición del crecimiento.
¿Cuáles son las consecuencias en la práctica?
Este estudio permite comprender los mecanismos implicados en la disbiosis asociada a la mucoviscidosis en lo que respecta a E. coli. Para corregir esta disbiosis y limitar la inflamación intestinal, al menos en parte, es importante optimizar la absorción intestinal de las grasas para reducir la cantidad de glicerol. Así, la mejora de la barrera intestinal, y especialmente de la mucosa, en esta enfermedad podría reducir la disponibilidad de oxígeno necesaria para el crecimiento de estas cepas de E. coli.
Conclusión
En casos de mucoviscidosis, la elevada cantidad de glicerol presente en el intestino como consecuencia de la malabsorción de grasas provoca la adaptación de E. coli y una proliferación clonal. La comprensión de los mecanismos subyacentes podría permitir el desarrollo de nuevos enfoques terapéuticos, además de mejorar el tratamiento de los enfermos.